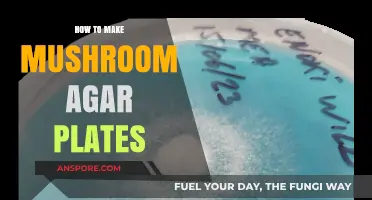
Mastering Mushroom Agar Plates: A Step-by-Step Guide for Beginners

Mushroom aglio olio is a delightful twist on the classic Italian pasta dish, combining the earthy richness of mushrooms with the bold flavors of garlic, chili flakes, and olive oil. This simple yet satisfying recipe elevates the traditional aglio olio by adding sautéed mushrooms, which bring a savory depth and umami quality to the dish. Perfect for a quick weeknight meal or a cozy dinner, this recipe requires minimal ingredients but delivers maximum flavor. With its harmonious blend of textures and tastes, mushroom aglio olio is a must-try for pasta lovers and mushroom enthusiasts alike.
Explore related products
What You'll Learn
- Ingredients: Gather spaghetti, mushrooms, garlic, chili flakes, olive oil, parsley, salt, pepper, and Parmesan
- Prep Work: Slice mushrooms, mince garlic, chop parsley, and grate Parmesan cheese
- Cook Pasta: Boil spaghetti until al dente, reserve pasta water, then drain
- Sauté Mushrooms: Sauté mushrooms in olive oil until golden and slightly crispy
- Combine & Serve: Toss pasta with mushrooms, garlic, chili flakes, and pasta water. Garnish and serve

Ingredients: Gather spaghetti, mushrooms, garlic, chili flakes, olive oil, parsley, salt, pepper, and Parmesan
To begin crafting your mushroom aglio olio, the first step is to gather all the necessary ingredients. Start with the foundation of the dish: spaghetti. Choose a high-quality pasta that holds its texture well, as it will be the base of your meal. Next, select mushrooms—cremini or button mushrooms work well, but feel free to experiment with varieties like shiitake or oyster for a deeper flavor. Ensure they are fresh, firm, and free of blemishes. Garlic is a star ingredient in aglio olio, so pick plump, fresh cloves that are easy to peel and mince. You’ll need enough to infuse the oil with robust garlic flavor.
In addition to the spaghetti and mushrooms, chili flakes are essential for adding a subtle heat to the dish. Adjust the quantity based on your spice preference, but a pinch to a teaspoon is typically sufficient. Olive oil serves as the cooking medium and flavor carrier, so opt for extra virgin olive oil for its rich, fruity notes. Fresh parsley will add a burst of color and freshness to the finished dish, so ensure it’s vibrant and fragrant. Don’t forget salt and pepper for seasoning—these will enhance the natural flavors of the mushrooms and garlic.
Another key ingredient is Parmesan cheese, which will add a salty, umami finish to the dish. Choose a block of Parmesan to grate fresh, as pre-shredded versions often lack the same depth of flavor. When gathering these ingredients, consider their quantities based on the number of servings. For a standard recipe serving 2-4 people, you’ll typically need 8-10 ounces of spaghetti, 8 ounces of mushrooms, 4-6 garlic cloves, and a handful of parsley.
As you prepare to cook, take a moment to organize your ingredients. Mince the garlic and chop the parsley in advance to streamline the cooking process. Clean and slice the mushrooms evenly to ensure they cook uniformly. Having everything measured and ready will make the actual cooking process smoother and more enjoyable.
Finally, ensure your pantry is stocked with salt and pepper for seasoning throughout the cooking process. These basic staples are often overlooked but are crucial for balancing the flavors of the dish. With all your ingredients gathered and prepped, you’re now ready to move on to the next steps of cooking your mushroom aglio olio.
Delicious Homemade Spaghetti Sauce with Mushrooms: A Simple Recipe
You may want to see also

Prep Work: Slice mushrooms, mince garlic, chop parsley, and grate Parmesan cheese
Before you start cooking your mushroom aglio olio, proper prep work is essential to ensure a smooth and efficient cooking process. The first step is to slice the mushrooms. Choose a variety of mushrooms such as cremini, shiitake, or button mushrooms, and clean them gently with a damp cloth or paper towel to remove any dirt. Slice the mushrooms evenly, about ¼ inch thick, to ensure they cook at the same rate. This will also give your dish a consistent texture and appearance.
Next, mince the garlic, as it's the star of aglio olio. Peel the garlic cloves and remove any excess skin or green sprouts, which can be bitter. Using a sharp knife, finely chop the garlic into small, even pieces. You can also use a garlic press or mince it with a mezzaluna for a more uniform texture. Aim for a fine mince, as this will allow the garlic flavor to infuse the oil and coat the pasta more effectively.
While you're working with the garlic, chop the parsley to add a fresh, herbal note to your dish. Rinse the parsley thoroughly and pat it dry with a clean kitchen towel. Remove the leaves from the stems and discard the stems. Finely chop the parsley leaves, ensuring a consistent size. You can also use a pair of kitchen scissors to snip the parsley into small pieces. Set aside the chopped parsley for garnishing your mushroom aglio olio later.
Lastly, grate the Parmesan cheese to add a nutty, umami flavor to your dish. Use a block of high-quality Parmesan cheese and a microplane or box grater to create fine, fluffy gratings. Grating the cheese yourself will yield a fresher, more intense flavor compared to pre-grated cheese. Be sure to grate enough cheese for both the recipe and extra for serving at the table. Properly prepared ingredients will not only make your cooking process more enjoyable but also elevate the final taste and presentation of your mushroom aglio olio.
As you prepare these ingredients, keep them organized and within reach of your cooking area. You can use small bowls or plates to hold the sliced mushrooms, minced garlic, chopped parsley, and grated Parmesan cheese. This will make it easier to add them to the pan at the right time and ensure a seamless cooking experience. With your prep work complete, you'll be ready to move on to the next steps of cooking your delicious mushroom aglio olio. Remember, taking the time to properly prepare your ingredients will pay off in the end, resulting in a flavorful and satisfying dish.
In addition to the above prep work, consider the timing of each task. You can slice the mushrooms and let them sit while you mince the garlic and chop the parsley. This will allow the mushrooms to release some of their moisture, which can be useful when cooking. Grating the Parmesan cheese can be done just before serving, as it will stay fresh and flavorful. By planning your prep work and multitasking efficiently, you'll be able to focus on the cooking process and create a truly exceptional mushroom aglio olio. With all your ingredients prepared and ready, you're now set to bring your dish to life.
Perfectly Crispy Garlic Mushrooms: Easy Recipe for a Tasty Appetizer
You may want to see also

Cook Pasta: Boil spaghetti until al dente, reserve pasta water, then drain
To begin the process of making mushroom aglio olio, the first crucial step is to cook the pasta to perfection. Start by bringing a large pot of salted water to a rolling boil. The general rule for salting pasta water is to use about 1 to 2 tablespoons of salt per pound of pasta, ensuring the water tastes slightly salty, akin to seawater. This step is essential as it seasons the pasta from within, enhancing its overall flavor. Once the water is boiling, add the spaghetti and stir gently to prevent the strands from sticking together.
The goal is to cook the spaghetti until it reaches the *al dente* stage, which means it should be cooked through but still firm to the bite. The cooking time can vary depending on the brand and type of spaghetti, so it’s important to follow the package instructions as a guideline. However, the best way to determine doneness is to taste a strand about 1 to 2 minutes before the suggested cooking time is up. *Al dente* pasta will have a slight resistance when bitten into, ensuring it doesn’t become mushy when combined with the sauce later.
While the pasta is cooking, it’s crucial to reserve some of the pasta water before draining. This starchy water is a key ingredient in creating a cohesive sauce that clings well to the pasta. Use a measuring cup or a ladle to scoop out about 1 to 1.5 cups of the pasta water and set it aside. The starch in the water will help emulsify the sauce, allowing it to coat the spaghetti and mushrooms evenly in the final steps of the dish.
Once the spaghetti is *al dente*, promptly drain it in a colander. Be careful not to rinse the pasta, as this will wash away the starch needed for sauce adherence. Shaking the colander gently to remove excess water is sufficient. At this point, the pasta is ready to be tossed with the flavorful mushroom and garlic sauce, but it’s important to move quickly to the next steps while the pasta is still hot, ensuring the flavors meld together seamlessly.
Finally, keep the drained spaghetti nearby as you prepare the mushroom aglio olio sauce. The reserved pasta water should also be within reach, as you may need to add it gradually to adjust the consistency of the sauce. This simple yet precise approach to cooking the pasta forms the foundation of a successful mushroom aglio olio, ensuring the dish is both delicious and well-balanced.
Easy Kadai Mushroom Dry Recipe: Spicy, Flavorful, and Quick to Make
You may want to see also
Explore related products

Sauté Mushrooms: Sauté mushrooms in olive oil until golden and slightly crispy
To begin the process of sautéing mushrooms for your mushroom aglio olio, start by selecting the right type of mushrooms. Button, cremini, or shiitake mushrooms work exceptionally well due to their firm texture and rich flavor. Clean the mushrooms gently with a damp cloth or brush to remove any dirt, as washing them can make them soggy. Slice the mushrooms uniformly, about ¼ inch thick, to ensure even cooking. This preparation is crucial for achieving the desired golden and slightly crispy texture.
Next, heat a large skillet over medium-high heat and add a generous amount of olive oil—enough to coat the bottom of the pan. Olive oil is ideal for this step as it adds a fruity flavor that complements the earthy taste of the mushrooms. Allow the oil to heat for about 30 seconds; it should be shimmering but not smoking. Carefully add the sliced mushrooms to the pan in a single layer, avoiding overcrowding, which can cause them to steam instead of sauté. If necessary, cook the mushrooms in batches to maintain even heat distribution.
As the mushrooms cook, resist the urge to stir them immediately. Let them sit for 2-3 minutes to allow one side to develop a golden crust. Once they’re nicely browned, stir or flip them to cook the other side. Continue sautéing for another 3-4 minutes, stirring occasionally, until the mushrooms are golden brown and slightly crispy around the edges. This step is key to enhancing their flavor and texture, ensuring they become a standout ingredient in your aglio olio.
While sautéing, season the mushrooms lightly with salt and pepper to enhance their natural flavors. Be mindful not to add salt too early, as it can release moisture and prevent the mushrooms from crisping up. If desired, add a minced garlic clove or two during the last minute of cooking to infuse the mushrooms with a subtle garlic aroma, which pairs beautifully with the aglio olio theme. However, be cautious not to burn the garlic, as it cooks quickly.
Once the mushrooms are golden and slightly crispy, remove them from the skillet and set them aside on a plate lined with a paper towel to absorb any excess oil. This step ensures that the mushrooms retain their texture and don’t make the final dish greasy. The sautéed mushrooms are now ready to be tossed with the cooked pasta, garlic-infused olive oil, and other aglio olio components, adding a delightful earthy and crispy contrast to the dish.
Crafting Whimsical Hot Glue Mushrooms: A Step-by-Step DIY Guide
You may want to see also

Combine & Serve: Toss pasta with mushrooms, garlic, chili flakes, and pasta water. Garnish and serve
Once your pasta is cooked al dente and your mushroom-garlic mixture is ready, it’s time to bring everything together in the final steps of making mushroom aglio olio. Start by reserving about 1 cup of the pasta cooking water, as it will be essential for creating a smooth, cohesive sauce. Drain the pasta, then immediately transfer it to the skillet or pan where the mushrooms, garlic, and chili flakes are waiting. The heat should be on medium-low at this point to prevent burning. Toss the pasta vigorously with the mushroom mixture, allowing the flavors to meld. Add a splash of the reserved pasta water to loosen the sauce and help it cling to the pasta. The starch from the pasta water will also create a creamy, silky texture that binds everything together.
As you toss the pasta, continue to add pasta water gradually, one tablespoon at a time, until the sauce reaches your desired consistency. Be careful not to overdo it—you want the sauce to coat the pasta without making it soggy. The goal is to achieve a light, glossy coating that enhances the earthy mushrooms and aromatic garlic. Keep tossing for about 1-2 minutes to ensure the pasta is evenly coated and heated through. The chili flakes should distribute evenly, adding a subtle heat that complements the dish.
Once the pasta is well combined, remove the pan from the heat. This step is crucial to prevent overcooking and to preserve the freshness of the ingredients. Now is the time to add any finishing touches that will elevate the dish. Drizzle a generous amount of high-quality extra virgin olive oil over the pasta, as it adds richness and depth to the aglio olio. Toss once more to incorporate the oil, ensuring every strand of pasta is glistening.
Garnishing is the final step to make your mushroom aglio olio visually appealing and even more flavorful. Sprinkle freshly chopped parsley or basil over the pasta for a burst of color and freshness. Grate a generous amount of Parmesan or Pecorino cheese on top for a salty, umami finish. If you prefer a nutty texture, you can also add a handful of toasted breadcrumbs or pine nuts. These garnishes not only enhance the presentation but also add layers of flavor and texture to the dish.
Serve the mushroom aglio olio immediately while it’s hot and fragrant. Use a large serving platter or individual bowls, ensuring the garnishes are evenly distributed. A final drizzle of olive oil or a squeeze of lemon juice can brighten the dish just before serving. This dish is best enjoyed fresh, as the flavors are at their peak right after combining. Pair it with a crisp white wine or a simple green salad for a complete meal. With its perfect balance of earthy mushrooms, garlicky goodness, and spicy chili flakes, this mushroom aglio olio is sure to impress.
Simple Steak and Mushroom Pie Recipe: Easy Homemade Comfort Food
You may want to see also
Frequently asked questions
You'll need spaghetti or your preferred pasta, mushrooms (such as cremini or shiitake), garlic, red pepper flakes, olive oil, parsley, Parmesan cheese, salt, and black pepper.
Clean the mushrooms by wiping them with a damp cloth or brushing off dirt. Slice them thinly or into bite-sized pieces for even cooking.
Yes, dried pasta works perfectly. Cook it according to the package instructions until al dente, then reserve some pasta water before draining.
Sauté the minced garlic in olive oil over medium-low heat, stirring frequently, until it’s fragrant and lightly golden. Avoid high heat to prevent burning.
Traditional aglio olio is cream-free, but if you prefer a creamy version, you can add a splash of heavy cream or use pasta water to create a lighter sauce. Keep it simple for an authentic taste.